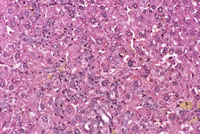
Toxic Change (Hepatopathy)

The Digitized Atlas of Mouse Liver Lesions

Much of the work carried out by DTT is in support of the National Toxicology Program (NTP), an interagency partnership of the Food and Drug Administration, National Institute for Occupational Safety and Health, and NIEHS.
Visit the NTP WebsiteToxic change and hepatopathy are generic terms sometimes useful to describe a constellation of individual degenerative, inflammatory, and proliferative changes that otherwise would need to be individually documented and graded. Some pathologists utilize this terminology in addition to documenting the individual components of the specific process (e.g., hepatocyte degeneration, fatty change, oval cell hyperplasia, pigment deposition, etc.). If one chooses to exclusively utilize a generic term for individual animals or even treatment groups, it will be necessary to define accurately that term in an accompanying pathology narrative.
Fatty change and pigment accumulation within Kupffer cells along with proliferation of sinusoidal lining cells are features of toxic change in this liver.
Numerous aggregates of pigment-filled Kupffer cells and associated proliferation of small cells with basophilic nuclei are present in this liver from a mouse chronically treated with methylclophenate. Higher magnification shows small basophilic cells which are proliferating oval cells. Phagocytosized pigment is present in Kupffer cells.